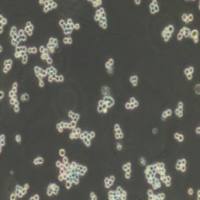
RAMOS人B淋巴细胞瘤细胞(提供STR鉴定报告)

相关产品推荐更多 >
万千商家帮你免费找货
0 人在求购买到急需产品
- 详细信息
- 文献和实验
- 技术资料
- 品系:
小鼠黑色素瘤带荧光素酶;B16luc
- 细胞类型:
小鼠黑色素瘤带荧光素酶;B16luc
- 肿瘤类型:
/
- 供应商:
优利科(上海)生命科学有限公司
- 库存:
100
- 英文名:
B16luc
- 生长状态:
贴壁生长
- 年限:
永久
- 运输方式:
快递形式
- 器官来源:
小鼠黑色素瘤带荧光素酶;B16luc
- 是否是肿瘤细胞:
是
- 细胞形态:
正常
- 免疫类型:
/
- 物种来源:
小鼠黑色素瘤带荧光素酶;B16luc
- 相关疾病:
/
- 组织来源:
小鼠黑色素瘤带荧光素酶;B16luc
- 规格:
T25培养瓶
该细胞源于C57BL/6J小鼠黑色素瘤,可以产生黑色素,同基因小鼠体内移植可成瘤
| 细胞英文名称 | B16luc | 细胞中文名称 | 小鼠黑色素瘤带荧光素酶 |
| 形态特性 | 上皮样 | 生长特性 | 贴壁生长 |
| 培养体系 | 1640+10%FBS | ||
| 传代方法 | 1:3传代,2-3天换液一次 | 传代情况 | |
| 冻存条件 | 无血清细胞冻存液 | ||
| 备注 | 悬浮细胞离心收集 | ||
STR:



1、 细胞传代:
1)细胞生长至覆盖培养瓶的 80%面积时,弃 25cm2 培养瓶中的培养液,用 PBS 清洗细胞一次;
2)添加 0.25%胰蛋白酶消化液约 1ml 至培养瓶中,倒置显微镜下观察,待细胞回缩变圆后加入 5ml 完全培养
液终止消化,再轻轻吹打细胞使之脱落,然后将悬液转移至 15ml 离心管中, 1000rpm 离心 5min;
3)弃上清,沉淀细胞用 1-2ml 完全培养基重悬,然后按 1:2 比例进行分瓶传代,最后放入 37℃, 5%CO2 细胞
培养箱中培养;
2、 细胞冻存:
1)细胞生长至覆盖培养瓶的 80%面积时,弃 25cm2 培养瓶中的培养液,用 PBS 清洗细胞一次;
2)添加 0.25%胰蛋白酶消化液约 1ml 至培养瓶中,倒置显微镜下观察,待细胞回缩变圆后加入完全培养液终
止消化,轻轻吹打细胞使之脱落,然后将悬液转移至 15ml 离心管中, 1000rpm 离心 5min;
3)用适量的冻存液(FBS: DMSO=9 : 1)重悬细胞,并放置于冻存管中;
4)先将细胞冻存管放置于-20℃ 1.5h,然后将其移入-80℃过夜, 24h 后转入液氮中进行长期保存。使用程序
降温盒可直接放入-80℃。
3、细胞复苏:
1)从液氮中取出细胞冻存管(注意:佩戴防爆管面具),快速将其置入 37℃水浴中解冻,直至冻存管中无结
晶,然后用 75%的酒精擦拭冻存管外壁;
2)将冻存管中的细胞移至含 6ml 完全培养基的 15ml 离心管中, 1000rpm 离心 5min;
3)弃上清,沉淀用 6ml 完全培养基重悬,接种 25cm2 培养瓶,于 37℃, 5%CO2 细胞培养箱中培养


小鼠黑色素瘤带荧光素酶;B16luc收到后处理
细胞在培养瓶中培养至良好状态后灌满完全培养液并封好瓶口是细胞运输的最好办法。收到细胞回到自己的实验室后,先打开外包装,用75%酒精喷洒整个瓶消毒后放到超净台内,严格无菌操作。镜下观察:未超过80%汇合度时,可将瓶装的完全培养液移入废液缸中,悬浮细胞需离心处理,加入6ml新鲜完全培养基,放入37℃、5%CO2孵箱培养;超过80%汇合度时,根据情况传代或者冻存,具体操作见细胞培养步骤说明书。
风险提示:丁香通仅作为第三方平台,为商家信息发布提供平台空间。用户咨询产品时请注意保护个人信息及财产安全,合理判断,谨慎选购商品,商家和用户对交易行为负责。对于医疗器械类产品,请先查证核实企业经营资质和医疗器械产品注册证情况。
文献和实验的新陈代谢来补充这种能量,因此 Goun 想要研究 NR 在癌症发展和扩散中的作用。 通过使用 BiNR 探针,研究人员对四种人乳腺癌细胞系(MDA-MB-231-luc、MDA-MB-468-luc、MCF-7-luc 和 BT-20-luc)的烟酰胺核糖摄取进行了量化,并发现一种高侵略性的三阴乳腺癌细胞系对于烟酰胺核糖的摄取率最高。 接下来,他们 MDA-MB-231 异种移植肿瘤利用小鼠模型,探索烟酰胺核糖是否会增加癌症发病和转移。令人惊讶的是,研究结果显示,烟酰胺核糖的补充会导致小鼠
魔高一尺,道高一丈!清华大学徐萌团队发现能量代谢与肿瘤免疫逃逸的关系
, GZMB, and PRF1)定义了 cytotoxic T lymphocyte (CTL) score,反映肿瘤浸润 CD8+ T 细胞的功能。 研究发现在表观转录组调控因子中,RNA 去甲基化酶 FTO 与 CTL score 呈现负相关。为了检测肿瘤细胞的 FTO 表达是否影响 T 细胞介导的抗肿瘤功能,研究人员在 B16-OVA 黑色素瘤细胞和肺癌细胞系 LLC 中对 FTO 进行敲降。研究人员将 B16-OVA 和 LLC 接种到小鼠体内,发现 Fto-Kd 细胞产生的肿瘤生长速度明显减慢
Nature:癌症疫苗新突破!调动 T 细胞与 NK 细胞的双重攻击,全面杀灭癌细胞
免疫 4 个月后,他们用肿瘤细胞重新攻击无肿瘤小鼠,发现其可完全受到保护。 另外,利用两个自发转移模型,B16-BL6 黑色素瘤模型和 4T1 三阴性乳腺癌模型。他们发现在切除原发肿瘤后,小鼠在接种了 MICB-vax 或 Ctrl-vax 后,MICB-vax 可显著降低两种模型术后 1 个月以上的肺转移数量。肺组织切片的组织学分析进一步表明,与 Ctrl-vax 相比,MICB-vax 可显著减少转移数量和转移大小。 他们还在恒河猴中检测了疫苗的安全性和免疫原性,发现抗 MICA 和抗 MICB